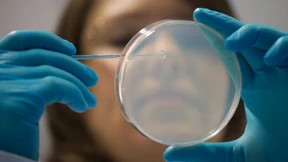
Ethikrat warnt vor Missbrauch von Bioforschung

Kein neuer Typ, trotzdem gefährlich
In Berlin sind mehr als 450 Menschen an Masern erkrankt. Beim Robert Koch-Institut verfolgt man die internationale Debatte über den Schutz. Längst ist die Frage aufgetaucht, ob man Babys früher impfen sollte.

In Berlin sind mehr als 450 Menschen an Masern erkrankt. Beim Robert Koch-Institut verfolgt man die internationale Debatte über den Schutz. Längst ist die Frage aufgetaucht, ob man Babys früher impfen sollte.

Deutsche Unternehmen ereilt in diesen Tagen eine Welle an Krankmeldungen. Weil die Viren sich wandeln, wirken die Grippeimpfstoffe nicht. Das Robert-Koch-Institut meldet „stark erhöhte Influenzaaktivität“.

Neue Zahlen des Robert-Koch-Instituts zeigen: Die Grippewelle in Deutschland ist noch längst nicht zu Ende. Der Virustyp H3N2 hat besonders viele Menschen infiziert.

Die Hessen leiden unter der Grippewelle, war doch 2014 ein mildes Grippe-Jahr. Lange Wartezeiten in Arztpraxen sind die Folge. Das Problem: Auch Patienten, die geimpft worden sind, kann wohl die Grippe treffen.

Ein Masern-Ausbruch und politische Versäumnisse: Wie eine Dahlemer Initiative in Flüchtlingsnotunterkünften Lücken schließen will, die von der Politik sträflich übersehen werden.

Ausgerechnet im kalifornischen „Disneyland“ nahm eine Masernepidemie ihren Ausgang. Die Behörden melden, dass viele Infizierte sich bewusst nie hatten impfen lassen. Auch in Berlin treten Fälle auf. Bringen die Infektionsserien die Wende in der Impfdebatte?

Die Zuckerkrankheit breitet sich rasend schnell aus. 6,7 Millionen Deutschen sind schon Diabetiker. Die Bundesregierung will den Kampf aufnehmen. Eine nationale Strategie soll verabschiedet werden, um die "Wohlstandskrankheit" einzudämmen

Die deutschen Risikoexperten warnten in diesem Jahr erstmals mit Nachdruck vor einer bakteriellen Infektion, die bislang vor allem Stallarbeiter, Tierärzte und Erdbeerpflücker traf. Nun könnten auch weitere Bevölkerungsgruppen gefährdet sein - etwa durch Haustiere.

Männer leben ungesünder und sterben früher als Frauen, heißt es in einer neuen Analyse des Robert Koch-Instituts. Männer neigen eher zu Süchten und Risikoverhalten und machen nicht ausreichend lange Sport.

Deutschland hat im internationalen Kampf gegen Ebola wenig geleistet. Nach Monaten des Zauderns soll nun die Hilfe beginnen – viel zu spät.

Die Bundesregierung hat ein Evakuierungsflugzeug in Betrieb genommen, mit dem Ebola-Kranke aus Westafrika ausgeflogen werden können. Das ehemalige Passagierflugzeug verfügt nun über eine „Sonder-Isolationseinheit“.

Herbstzeit – Erkältungszeit. Spätestens wenn die Grippewelle anrollt, greifen viele Verbraucher zu Seifen und Waschlotionen mit antimikrobiellen Zusatzstoffen. Doch die nützen wenig und schaffen neue Probleme.

Milliarden von Suchanfragen gehen jeden Tag bei Google ein. Daraus lässt sich eine ganze Menge lernen. Zum Beispiel, wie sich das Grippevirus verbreitet. Berlin ist als Erstes dran.

Unkoordiniert und überhastet: So nennt das Weiße Haus Medienberichten zufolge die Ebola-Quarantäne, die mehrere amerikanische Bundesstaaten angeordnet hatten. Diese soll nun wieder aufgehoben werden.
Der im Leipziger Klinikum St. Georg behandelte Ebola-Patient ist tot. Der 56 Jahre alte UN-Mitarbeiter erlag der Infektion in der Nacht.

Kann sich Ebola bis nach Deutschland ausbreiten? An Flughäfen gibt es viele Kontrollen. Aber afrikanische Flüchtlinge kommen mit dem Zug oder in den Autos der Schlepper. Was Behörden und Fachleute zu diesem Szenario sagen.

Ein Infizierter liegt in einem deutschen Krankenhaus. Fachleute meinen, die Seuche kann sich nicht ausbreiten. Doch was, wenn Ärzte und Pfleger Fehler machen?

Viele Schwangere fürchten, sich durch Lebensmittel mit Listeriose zu infizieren. Amerikanische Mediziner einigten sich nun auf ein stringentes Therapieschema, wie mit Verdachtsfällen verfahren werden soll.

Kontaminiert man eine Türklinke in einem öffentlichen Gebäude mit einem Virus, breitet es sich rasend schnell aus. Nur eins hilft dagegen, ergibt eine Studie.

Die Ebola-Seuche zieht immer weitere Kreise, die Opferzahlen steigen ungebrochen. Präsident Obama warnt vor einer weltweiten Gesundheitskrise. Die Bundesregierung will deutsche Infektiologen nach Afrika schicken. Und Sierra Leone verhängt eine umstrittene Ausgangssperre.

Im Kampf gegen Ebola will Deutschland eigene Experten nach Afrika entsenden. Derweil versucht Sierra Leone die Verbreitung der tödlichen Seuche mit einer viertägigen landesweiten Ausgangssperre einzudämmen.

Mehr Mädchen sollen vor dem sexuell übertragbaren Humanen Papillom-Virus geschützt werden. Deshalb empfiehlt die Ständige Impfkommission nun, jüngere Kinder zu immunisieren. Auch andere Impfschemata wurden überarbeitet.

In den Ferien gibt es weniger Blutspender. Doch auch nach dem Urlaub dürfen nicht alle sofort wieder spenden. Für manche ist es sogar immer verboten. Ein Gespräch mit Stefanie Fritzsche vom Deutschen Roten Kreuz.

Machtlos schauen wir Europäer auf die Epidemie in Afrika – und stellen uns bange Fragen. Warum erreicht die Seuche dieses Ausmaß? Und: Was heißt das für uns?

Die Weltgesundheitsorganisation will mit allen Mitteln verhindern, dass sich Ebola in Westafrika weiter ausbreitet. Mit einem 100-Millionen-Dollar-Programm will sie den Kampf gegen das tödliche Virus „auf ein neues Niveau heben“. Die Ärzte ohne Grenzen sind skeptischer: „Die Lage ist außer Kontrolle.“

Jedes Jahr infizieren sich in Deutschland rund 3000 Menschen neu mit HIV. Doch die deutschen Ärzte fühlen sich nur unzureichend für den Umgang mit der Krankheit vorbereitet.

Die Deutschen trinken doppelt so viel Alkohol wie andere Nationen – und zahlen dafür einen hohen Preis: Etwa 15.000 Menschen sterben jährlich daran. Dabei wäre es gar nicht so schwer, daran etwas zu ändern, sagen Fachleute.

Einer Studie des Robert Koch-Instituts zufolge ist die Zahl der jungen Raucher deutlich zurückgegangen, der Alkoholkonsum sank ebenfalls. Doch die Studie gibt auch Anlass zu Sorge: Der soziale Status hat großen Einfluss auf die Gesundheit von Kindern.

Der Sommer ist da: Jetzt sollen Bauch und Po unbedingt straff werden. Sogenannte Fitness-Gurus machen es scheinbar mühelos vor. Doch trotz aller Mühen bleiben die Fettpolster oft, wo sie sind. Warum bloß?

Angesichts des Straßenverkehrs mag man es kaum glauben, aber die meisten Unfälle passieren im eigenen Zuhause.
Nicht nur für Wissenschaftler ist die Erforschung hochgiftiger Mikroorganismen und tödlicher Viren interessant. Auch Terroristen könnten die Ergebnisse für Anschläge mit Biowaffen nutzen. Der Deutsche Ethikrat mahnt Sicherheitsregeln an.

Als weltweit die Angst vor der Grippe-Pandemie umging, glaubten alle an die Mittel Tamiflu und Relenza. Millionen Arzneidosen wurden gekauft und eingelagert, Milliarden Euro ausgegeben. Jetzt zeigt sich: Die Mittel nützen kaum und schaden mehr als erhofft.

Wegen des milden Winters sind Zecken durchgängig aktiv gewesen. Sie übertragen Krankheitserreger, die zur Hirnhautentzündung führen können.

Allein der Name verbreitet Angst und Schrecken. Entwickelt die Pharmaindustrie etwas gegen Ebola? Und wie groß ist die Gefahr der Einschleppung nach Deutschland? Informationen rund um den Virus.

Tuberkulose galt bei uns lange als besiegte Krankheit, nun schlagen Experten Alarm: Die Erkrankung tritt wieder häufiger auf. Besondere Risikofaktoren sind Armut und Obdachlosigkeit.

Die neue Kälte täuscht, der Kalender auch: Das Risiko eines Zeckenstichs herrscht in großen Teilen Deutschlands inzwischen fast ganzjährig. Die ersten FSME-Infektionen im Jahr sind bestätigt. Wie alarmierend sind sie?